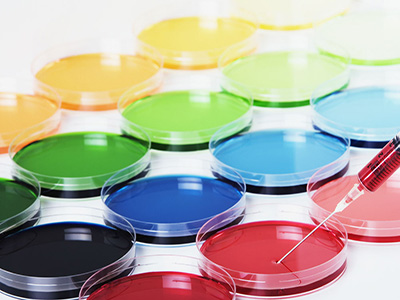
冠心病應該如何治療和用藥？

可選用鈣通道阻滯劑,硝酸脂類藥物,轉換酶抑制劑進行治療,心率較快者可選用β受體阻滯劑,以緩釋劑為好。可加用腸溶阿斯匹林100-325mg1/d,注意對冠心病危險因素的治療如降壓治療、調脂治療、治療糖尿病、戒煙、禁酒等。還可選用極化液和硝酸脂類藥物靜滴。合並心衰及心律失常時需加用糾正心衰及抗心律失常的治療(詳見心衰及心律失常篇),必要時可行冠心病的介入治療(PTCA+支架術),嚴重者可考慮進行外科搭橋手術。

在人到中年或過60歲的社會人群中,患冠心病的人並不稀見。因為有些人無自覺症狀,心電圖檢查正常。這屬於隱性冠心病,直到有間斷發生心髒病各種症狀時,才引起人們的注意。已經確診為患冠心病的病人,應該學會正確掌握幾種藥物,例如,硝酸甘油、消心痛、安定、中藥保心丸等的正確使用。冠心病發作時,病人都有自我感覺的先兆症狀,例如,心前區悶痛、絞窄感、恐懼感等等,可以根據自己以往的經驗自行服藥,就地休息,有條件時吸氧,可以得到很好的效果,不必等醫生,防止嚴重發作。要特別注意,不要免強堅持所進行的各種活動,危險常常發生在“堅持一下”之中!外出旅行、公務活動,應該攜帶隨身藥品。特別強調戒煙,心絞痛頻繁發作時禁止吸煙。
冠心病急性發作時的治療
1、心絞痛:
應立即停止體力活動,就地休息,設法消除寒冷,情緒激動等誘因;立即舌下含化硝酸甘油或消心痛1片,如未緩解,隔5到10分鐘再含化一次,連續3次含化無效,胸痛持續15分鐘以上者有發生心肌梗塞的可能,應立即送醫院等急救場所;可口服安定3毫克,有條件者應吸氧10到30分鐘。冠心病病人應隨身攜帶硝酸甘油等藥物,一旦出現胸痛立即含服,並注意不要使用失效的藥物。穩定型心絞痛在休息和含化硝酸甘油後心絞痛會緩解,不穩定型心絞痛是一個嚴重而潛在危險的疾病,應立即送醫院治療和嚴密觀察。
2、心肌梗塞:
急性心肌梗塞死亡率高,其中半數以上病人是在住院前死亡的,大多數死亡發生在發病後1小時內,一般由心室纖顫引起。所以就地急救措施和迅速轉送醫院至關重要。在高危病人(高血壓,糖尿病,既往有心絞痛發作者)中一旦發生以下情況:胸部不適,極度疲勞,呼吸困難,尤其伴有大汗,頭昏,心悸,瀕死感時,要高度懷疑發生了心肌梗塞,應立即送距離最近的,有條件作心電圖,心電監護,直流電除顫,靜脈溶栓的醫療機構。同時保持鎮靜,不要引起病人的驚慌和恐懼,並含化硝酸甘油,或者速效救心丸,冠心舒合丸等,有條件可肌注罂粟鹼,或杜冷丁,以及安定,並保持通風和吸氧,如無禁忌症,立即口服阿斯匹林300毫克。如發生室速,室顫等惡性心律失常立即予直流電除顫。一旦發生心髒驟停,應立即人工呼吸和胸外心髒按壓進行心肺復蘇。
3、急性心衰和心源性休克:
急性心肌梗塞和缺血型心肌病都可能發生急性心衰,由於大面積心肌壞死所致.多為急性左心衰,患者出現嚴重呼吸困難,伴煩躁不安,窒息感,面色青灰,口唇紫绀,大汗淋漓,咳嗽,咯大量白色或粉紅色泡沫痰,這種情況必須立即送醫院搶救。
冠心病的藥物、介入、手術搭橋治療
藥物只能控制症狀,能穩定冠狀動脈裡的斑塊。藥物是基礎,介入是最近20年發展起來的,2000年之後已經成熟起來,不僅僅是控制症狀,而且有可能徹底根治,把窄的血管撐起來。介入簡單、無創,不用開胸,而且立竿見影,技術上是高風險的,需要一定的培訓,有一定的條件才能做,也需要病人的配合。支架一旦形成血栓那就要出問題了,有1%的發生率。總體來說,現在人們除了追求生活以外還追求生活質量,一個40歲的男性,天天出去跑,要打高爾夫,要爬山,天天吃藥雖然不死但是覺得活的沒什麼意思,就要做介入。不能做介入的或者經濟條件比較差的,介入要做七八個支架才能解決,那干脆放棄,考慮搭橋。
實際上介入跟搭橋手術是一個東西,介入是把裡面的堵塞撐開疏通,搭橋是開胸從上游弄一根管子到下游去,重新開辟一條通道。從理論上來說,藥物、介入跟手術對低危的穩定病人效果一樣,做介入也好,做搭橋也好,吃藥也好,不會死人的,這是公認的研究結果。但是介入的治療過程中間對病人的手術損傷要大大小於外科手術,康復起來的時間要短很多,一般說來外科和介入有不同的手術適應症,一般會考慮患者的經濟適應能力和身體患病的具體情況.一百個40歲的人只要吃藥,或者介入,或者搭橋最後死的人都是一樣多的。介入治療的人可以爬香山,但是吃藥的人絕對不能爬山,搭橋的也可以爬。但是搭橋的人復發的少,介入的人復發的多,搭橋的人再狹窄的幾率小,現在有藥物支架,可預防復發,藥物支架和搭橋的復發率估計差不多。
中醫對此的治療手段或處方用藥
在治療上,適宜根據患者的臨床表現的不同而采用急則治標、緩則治本、先攻後補、先補後攻、攻補兼施等治療手法,切不能一攻到底或只知補虛而忽視疏導痰瘀。
1.心陽虧虛:
心陽不足為心氣不足的重症。古人說:“心包相火附於命門。”心陽不足的根源乃是命門火衰,立方以附子(用量為10g左右,本品有大毒,不可多用)、桂枝益腎中真火。《名醫方論》說:“火少則生氣,火壯則食氣”,故不用肉桂而用桂枝,且附、桂用量不大、其意思在於微微生火,以防過燥傷陰。補氣之品多用紅參(最好是高麗參或吉林參)。冠心病人都有不同程度的心脈瘀阻,所以多配以紅花、桃仁、丹參等活血化瘀藥。在活血化瘀的同時,還應注意理氣、行氣,意在調整髒腑的切機以調理氣血,去瘀生新。冠心病人的血瘀既可因寒而凝,也可因熱而結。寒凝瘀久且可化熱。凡熱結而瘀或瘀久化熱者,如仍用溫通之品,必然助熱傷陰。而應涼血化瘀,其意在於護陰。此外,冠心病患者亦有不同程度上的痰濁阻滯,故往往采用芳香化濁、溫化痰飲的法半夏、陳皮、天南星、蔻仁、春砂仁。但如蘊久化熱者仍用溫化之品,必助熱傷陰,此時必須清化。
2.心陰虛損:
冠心病者多見於老人,而老人常見素體陰虛。在病變過程中,多易出現陰虛尤其是腎陰虛的症候,久之陰損氣傷,或氣虛津液生成不足,都可出現氣陰兩虛的症候。因而適宜采用益氣養陰的方法治療。五味子、太子參、白芍、麥冬、石斛均為常用益氣養陰之品。雖藥味不多,而兼有補氣、清熱、滋陰、斂陽四法。養陰能增加氣血的來源,益氣能行血,故益氣養陰的同時,又能促進活血化瘀的作用。太子參、五味子、麥冬為生脈散,根據現代藥理研究,表明生脈散有穩定而持久的強心作用,對已經被損傷的冠狀動脈內壁有修補作用,同時還能穩定正常的血壓。